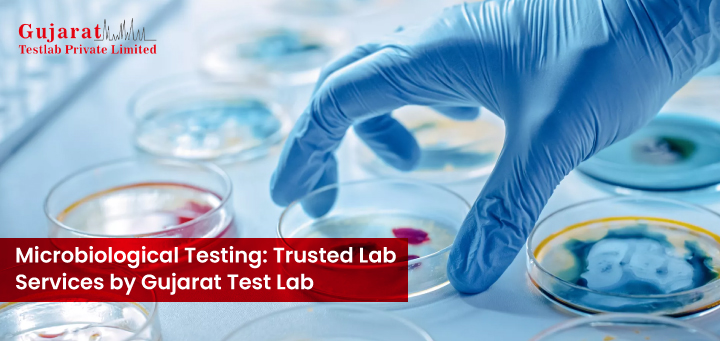

Latest Blogs
Accurate Food Microbiological Testing for Safety
3 June, 2025
Microbiological Testing: Trusted Lab Services by Gujarat Test Lab In today's speedy world, making sure your products are safe and of good quality is not just necessary. Whether you operate a food manufacturing unit, have a pharmaceutical line under your care, or handle water and cosmetics, the presence of pathogenic microorganisms could cause serious health hazards and loss of reputation to your brand. At Gujarat Test Lab, we specialize in food microbiological testing and other microbiological analysis services that make sure your business stays in compliance, consumers are protected, and products are of quality. Counting years of experience, an expert team, and advanced
Reliable Oil Lab Testing for Quality and Safety
29 March, 2025

Ensuring Quality and Safety: Comprehensive Oil Lab Testing at Gujarat Test Lab Oils and fats serve as the principal industrial raw materials for food processing, pharmaceuticals, cosmetics, and industrial applications. The quality and stability of oils and fats play a significant role in the safety and performance of the final products. Thus, oil lab testing is of utmost importance in providing maintenance supply standards for all the industries involved. Gujarat Test Lab specializes in oil lab testing that encompasses safety, compliance, and efficiency. Why is Oil Lab Testing Important?
Significance of Pesticide Testing in Food Safety: What You Should Know
30 November, 2024

When a person starts eating, the last thing he or she probably wants to worry about is whether the food is safe or not. The food may contain harmful chemicals including pesticides. While pesticides can protect crops from diseases and pests, they could leave residues on food. Here, pesticide testing laboratory’s role comes in. Such laboratories ensure that the food you eat is safe and free from harmful chemicals. Pesticide Testing in Food Safety is Important More than Ever Pesticides are chemicals which are used in farming to protect crops from weeds, fungi and oth
The Role of Sugar Product Testing Laboratories in Ensuring Quality and Safety
3 September, 2024

Sugar is an essential ingredient in countless food and beverage products, from candies and baked goods to soft drinks and sauces. Given its widespread use, the quality and safety of sugar products are of utmost importance. This is where sugar product testing laboratories come into play, ensuring that the sugar we consume is pure, safe, and meets all regulatory standards. What is a Sugar Product Testing Laboratory? A sugar product testing laboratory is a specialized facility where various types of sugar and sugar-containing products are analyzed. These laboratories conduct a range of tests to determine the quality, purity, and safety of the sugar. The testing process can involve chem
How Food Testing Laboratory Ensure Safety and Quality
24 July, 2024

The quality of food we eat is the ultimate concern around the world. The concern begins right at the source where the ingredients are grown. Then it continues through the journey of production, distribution, and preparation until the food reaches your plate. This blog talks about how the food testing laboratories ensure the safety and quality of the food consumed by us. Food testing laboratory is not just a testing facility but they are the unsung heroes of the food supply chain. The food testing labs make sure to use advanced systems and technologies to operate diligently. They ensure the food offerings are safe for consumption and delicious as well. How Food Testing Laboratory
The Importance of Microbiological Testing in Cosmetic Product Safety
24 June, 2024

Microbiological testing is carried out to ensure quality and safety of the product. Cosmetic product testing laboratories conduct microbiological testing to ensure that the product is free from harmful microorganisms. Such microorganisms can cause spoilage, infections and other adverse health effects on humans. Significance of Microbiological Testing in Cosmetic Products Consumer safety: Pathogenic microorganisms like yeast, moulds or other bacteria can cause skin infections or eye infections. To prevent these infections from bei
The Importance of Testing Drinking Water: Ensuring Safety and Quality
27 May, 2024

Water is an essential component of life. It is vital to have access to clean drinking water to maintain overall well-being of a person. Due to contamination and pollution, it has become challenging to ensure the quality and safety of drinking water. This is where a water testing laboratory plays a role. Why We Need to Test Drinking Water? Testing Drinking water helps to identify contaminants which might be present in your water. These contaminants may include Bacteria, heavy metals, pesticides, chemicals, etc. Detection of such contaminants early can help mitigate health risks. It can prevent potential outbreaks of waterborne disease. Moreover, regular testing of wat
Why water testing is required
7 September, 2020

Water is a transparent, odorless, tasteless, chemical substance composed of the chemical elements hydrogen and oxygen. It is one of the most important and essential compounds. Water is the main component of Earth’s Hydrosphere and the main fluids of all living entities. There is the same amount of water on Earth as there was when the Earth was formed. Almost 97% of the world’s water is non-drinkable or salty. Water covers 71% of Earth’s surface, mostly as ocean and seas. Only a small portion of water is drinkable which comes as groundwater (1.7%). That’s why it is important to test the water to make groundwater as drink water. Let’s see some reasons why water quality testing is important. Regular
Why Food testing is important in India?
31 December, 1969

Though it may be the last process of the food manufacturing chain, food product testing is the most important step, because it determines the safety of the food for use. In India, the rules set by FSSAI are strictly monitored. Consumers stay away from food products that do not fulfill the FSSAI requirements. Food product testing is vitally necessary, to ensure that the food is free of physical, chemical, and biological hazards. Examples of potentially hazardous food contaminants include metals, e-Coli bacteria, salmonella, cleaning agents, additives, preservatives, pesticides, and more. Food product testing is the scientific analysis of food and its contents. It is done to provide information about various cha
Milk Testing Lab
31 December, 1969

Milk has been enjoyed throughout the world. We all know that milk is a good source of calcium and protein. Apart from these, it is an excellent source of vitamins and minerals, potassium, B12, and omega 3. Milk; being a primary source of calcium, protein, and potassium; is also beneficial to maintain healthy bone structure. A large number of studies present in public domain suggests that the consumption of milk and dairy products reduces the risk of fractures and prevent osteoporosis. With numerous health benefits, milk is a versatile ingredient that can be added to human diet in a number of ways. Milk is important from humans but in today’s world milk adulteration has become a global concern. Unfortunately,
Water Testing Lab
31 December, 1969

Water is equalizing to life. It is the first requirement for every life on earth, hence it has to be pure, fresh and free of all harmful chemicals and pesticides. The earth has an abundance of water, but unfortunately, only a small percentage of about 0.3 percent, is usable by humans. It is the scarcity of drinking water that haunts all of us. To address the issues of water purity, Gujarat Test Lab has established a separate & specialized division for water analysis and water quality testing. It is one of the best and state of the art water testing lab that can analyse all sorts of water for home or industrial usage. The lab assures that the quality of water shouldn’t get compromised irrespective of its usage. Water is used f
Food Testing Lab in India
31 December, 1969

Data from the FSSAI shows that almost 13% of the 2.4 lakh product samples of various food items had failed laboratory tests since 2011. Food testing and appropriate certification from Food Testing Lab in India is must before the commercial production starts. It avoids all unnecessary health risk to public. Today’s food industry in India definitely demands food lab testing and inspection to ensure the good or acceptable quality and to protect public health. As adulteration is becoming